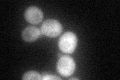
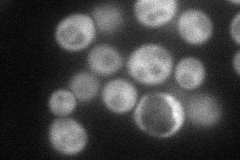
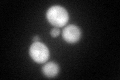
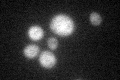

View description
Protein kinase implicated in activation of the plasma membrane H(+)-ATPase Pma1p in response to glucose metabolism; plays a role in ion homeostasis
Localization:
Intensity:
Fold change:
Significance:
-
C’ GFP library in SD
cytosol50.59 -
N' NOP1pr-GFP in SD
cytosol71.9127 -
N' TEF2pr-mCherry in SD

cytosol57.8196 -
N' NATIVEpr-GFP in SD

cytosol35.5661 -
N' TEF2pr-VC and Cyto-VN in SD

#N/A0 -
C’ GFP library in SD+DTT
cytosol57.051.12No -
C’ GFP library in SD+H2O2

cytosol61.241.21No -
C’ GFP library in Starvation Media
cytosol57.861.14No -
C’ GFP library on the background of Pup2-DaMP

cytosol -
C’ GFP library on the background of CCT mutant

cytosol43.09180.851611No
